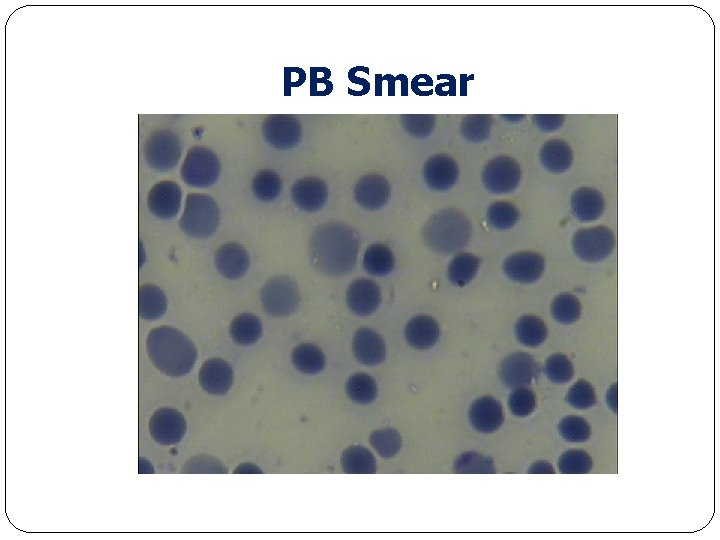
PB Smear

In the name of God Case presentation Immune






















- Slides: 22

In the name of God Case presentation Immune Hemolytic Anemia

Case presentation �Patient: Female DOB : 9/10/95 ( 29/12/2016) �Age: 5 MO � Second child , parents: First degree, 37 weeks, HC: 36 cm, 4400 gr, C/S duo to decrease of fetal movement �First Child : OK �Admission : Amir kola Hospital : 9/10/95 �CC & PE: Dyspnea , Cyanosis, Hepatosplenomegaly, Edema , Decrease O 2 saturation (So 2 < 30%) �VBG: PH: 7. 05 PCO 2: 79 SO 2 : 41% HCO 3 : 22

Work up � Impression : CHD and PFC � Diagnosis: Hydrops Fetalis - Non immune � First CBC: � WBC: 22300 RBC: 1. 33 Hb: 4. 5 � MCV: 112 MCH : 33 MCHC: 30 Plate : 85000 � Retic : 1. 4 % D-Coombs: neg � SGOT : 38 SG PT : 28 Alb: 2 Bil. T/D: 2. 3 / 0. 3 � G 6 PD : sufficient CRP : 14 high (135 , 68) � BG neonate : OMother A+ � CXR: Cardiomegaly � ECHO: RVE , LVE, TR, MR � Abdo Sonography : large liver , spleen Nl 11/10/95

Work up �Anti Parvo. Virus : Neg 22/10 /95 � (PCR PVB 19 : ? ? ? ) �Torch study & metabolic disorders �Management: � Intubation , Ventilation, AB-therapy , Surfactant & PG , Milrinon, Isovolume Exchange 165 cc ( 9/10/95 ) , packed cell transfusion ( 10/10 45 cc + lasix) �Discharge ; 26/10/95 good condition

Follow Up in AMIR KOLA HOSPITAL Follow Up : 1. 5 mo old ; visit : Anemia � Recommendation EP , ( Hb : 7) At first good response , ( Hb 10) � Again anemia : � 7/2/96 Admisson & visit of Hematologist � WBC: 13000 RBc: 2. 06 0. 000 Hb: 6 MCV : 86 MCh: 29 MCHC: 33 � Plate : Nl Retic : 0. 5 % Coombs : neg � 7/2/96 PC transfusion � Mother; RBC : 5. 800000 Hb : 13. 7 A 2 2. 5 % A; 97. 5 23 � Hb. E: Nl MCV : 71 � Father: RBC: 4. 45 Hb: 14 MCV : 88 NL � Erythropoietin level: 116 high(9/2/96) � Hb E patient : HB Barts: 43%? ? ? Hb. F; 4. 25% (13/2/96) HBA: 50% MCH : Hb : NL Hb. A 2: 1. 9%

Follow Up in AMIR KOLA HOSPITAL � 16/2/96 : HB: 6 Coombs : 1+ pos � PB 19 Mother : Neg �Infant PV B 19 Ig. G; 0. 5 (11/2/96) IVIG: Infusion � 23/2/96 : Hb : 6 Ig. M: 2. 3 pos

Work up / Mofid Hospital � Admission in Mofid hospital 25/2/96 Age : 4. 5 mo � PE: good baby , mild icter in sclera, Hepatomehgaly , pallor � WBC : 23300 N ; 51 % L ; 43 � RBC: 1. 800, 000 � MCV: 73 Hb : 5 MCH : 27 Plate : 540000 RDW: 17 Retic ; <0. 1 % � Coombs : Direct : 4+ Indirect : 1+ � Aniso, Hypo , Poikilo , Sper 1 -2 + � ALK : 986 Nl SGOT ; 340 SGPT : 546 LDH : 1156 � Urine ; nl q Coombs D/I , Ab scrennng mother: Neg q Antibody screning patient ; Tube method : Auto control: Pos 4+ q Strong Warm Auto. Ab Ig. G; 3+ Complement C 3 D : positive : 1+ � Drugs : IVIG 1 gr/kg x 4 days & Cortico (CS)

Work up / Mofid Hospital �CXR �ECHO : Nl � Abd Sono: Liver : 75 mm, liver span increase Spleen : Nl size � BMA : Increased Cellularity in M & E series 28/2/96

Bone Marrow

Bone Marrow

Bone Marrow

Work up / Mofid Hospital �Virology : Toxo (Patient) : Ig. G , Ig. M +( mild incease) �Infectous consult : No treatment � Eye Exam: Nl �Brain CT : Benign subarachnoid enlargment, No calcification �EBV & CMV: Neg PCR �Parvovirus B 19 PCR: positive �IG: Nl - Ig. G increased ( IVIG infusion) �Collagen vascular tests patient & Mother : Negative �Mother Torch : Neg �Thalassemia Gene Analysis: final result-Pending

Follow up / Mofid hospital �Duo to progressive rising of Retic to 14 -15% & high level of LFT and Gamma GT: 193 � GI consult : Immune , Viral , Giant cell hepatitis �Biopsy of Liver was done �Puls MP and 1 gr/kg Iv. Ig and Azathioperine 2 mg/kg /day/po �Duo to decrease Hb to 6. 5 and , persistant high Retic; Rituxmab : 375 mg/m 2 / Iv infusion x 4 weeks

Lab tests/Mofid hospital Date 26/2 28/2 29/2 2/3 3/3 6/3 7/3 9/3 11/3 14/3 10 6. 5 11. 4 7. 8 6. 9 11 9. 9 9. 6 9 8. 6 87 90 87 Hb 5 MCV 73 78 79 81 84 Retic <0. 1 <0. 5 7% 8% 14 % 11 % - 13% SGOT 340 488 156 103 235 131 104 SGPT 546 271 378 262 545 253 245 Bil. T/D 2. 7/ 1. 3 3. 7/ 0. 6 3. 2/ 1. 8 5. 5/ 0. 7 2. 8/ 0. 5 2. 8/ 1. 2 LDH 115 1 1800 93 15% 10% 900

Recent Lab tests Last CBC : 20/3/96 after Rituximab 2 � RBC : 2. 460. 000 � Hb: 8. 6 MCV: 95 MCH 34 MCHC: 36 � Retic : 5. 5% Coombs: 2+ � SGOT : 170 SGPT: 188 � BILT/D: 2. 2/0. 9 � Drugs: Azathioperinr and prednison( On taper), Acid Folic � pathology Report of liver Biopsy: � Mild Giant Cell transformation , Cholestasis, Mild microvesicular steatosis, and some asinar formation, work up for Metabolic disese

PB Smear

PB Smear

PB Smear
PB Smear

PB Smear

PB Smear

Thank You